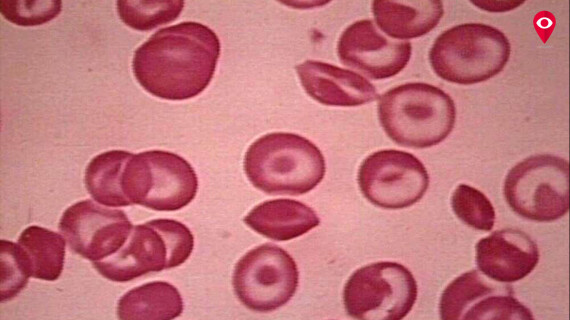

जगभरात 8 मे हा थॅलेसिमिया दिवस म्हणून पाळला जातो. थॅलेसिमिया हा एक गंभीर आजार आहे. या आजारापासून बचाव करण्यासाठी दोनच मार्ग आहेत. लग्नापूर्वी पती-पत्नीच्या रक्तची चाचणी केल्यास दोघांच्या रक्तात मायनर थॅलेसिमिया आढळल्यास त्यांच्या होणाऱ्या अपत्यास देखील हा आजार होण्याची पूर्ण शक्यता असते. त्यामुळे 10 आठवड्यांनी गर्भवती असलेल्या मातेची वेळोवेळी तपासणी होणे गरजेचे आहे. जेणेकरून होणाऱ्या अपत्याला हा आजार होणार नाही. दुसरा उपाय म्हणजे जर अपत्य जन्माला आल्यानंतर त्याला थॅलेसेमिया हा आजार झाल्याचे आढळल्यास बोन मॅरो ट्रान्सप्लांट पद्धतीने बाळाचे जीवन सुरक्षित केले जाऊ शकते.
जनुकिय बिघाड (जेनेटिक डिसऑर्डर) झाल्याने थॅलेसिमिया हा आजार होतो. या रोगात शरीरातील (हिमोग्लोबिन) रक्त निर्माण होण्याच्या प्रक्रियेत अडथळा येतो. ज्यामुळे शरीरात रक्ताची कमतरता होते. अशा वेळी रुग्णांच्या शरीरात लाल रक्तपेशींची संख्या 120 दिवसांच्या जागी 20 दिवस पुरेल इतकीच असते. त्यामुळे याचा प्रभाव सरळ शरीराच्या रक्तावर (हिमोग्लोबिन) पडतो आणि शरीरात रक्ताच्या कमतरतेमुळे अशक्तपणा आणि इतर आजार जडण्याची शक्यता असते. या आजारावर वेळीच उपचार करणे गरजेचे आहे. अन्यथा रुग्णाचा मृत्यू देखील होऊ शकतो.
थॅलेसिमियाचे दोन प्रकार कोणते?
थॅलेसिमियाचे दोन प्रकार असतात. माइनर थॅलेसिमिया आणि मेजर थॅलेसिमिया. माइनर थॅलेसिमियात फक्त एक गुणसुत्र प्रभावित होते. यामध्ये रुग्णाला रक्त पुरवठ्याची गरज कमी भासते. मात्र मेजर थॅलेसिमिया झाल्यास दोन्ही गुणसुत्रे निकामी होतात आणि रुग्णाला जास्त रक्तपुरवठ्याची गरज भासते. भारतात प्रत्येक वर्षाला जवळपास 10,000 जन्मजात मुलांमध्ये हा रोग आढळून येतो.
काय आहेत थॅलेसिमियाची लक्षणे?
अशक्तपणा
थकवा
अस्थी विकृती
शरीर पिवळे पडणे
शारीरिक विकास कमकुवत होणे
संक्रमणामुळे
आयर्न अधिभार
हृदयाच्या समस्या
या आजाराचे कसे कराल निवारण?
ब्लड ट्रान्सफ्युजन (रक्तपुरवठा)
अस्थीमज्जा प्रत्यारोपण
औषधे आणि शरीरातील अतिरिक्त लोह कमी करणे
पित्ताशय काढून टाकणे
